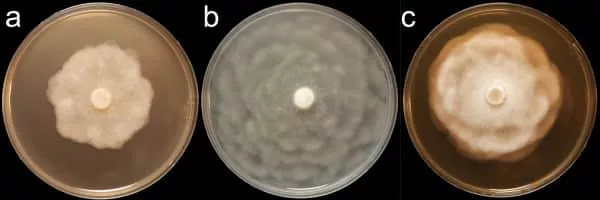
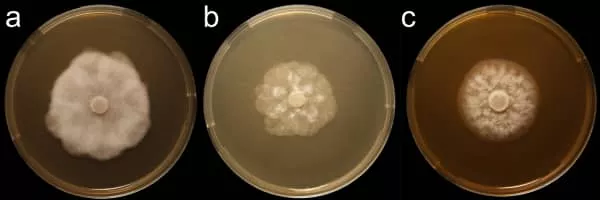

Phytophthora Erythroseptica
| Use attributes for filter ! | |
| Scientific name | Phytophthora erythroseptica |
|---|---|
| Rank | Species |
| Higher classification | Phytophthora |
| Date of Reg. | |
| Date of Upd. | |
| ID | 2242632 |
About Phytophthora Erythroseptica
Phytophthora erythroseptica—also known as pink rot along with several other species of Phytophthora—is a plant pathogen. It infects potatoes causing their tubers to turn pink and damages leaves. It also infects tulips damaging their leaves and shoots.